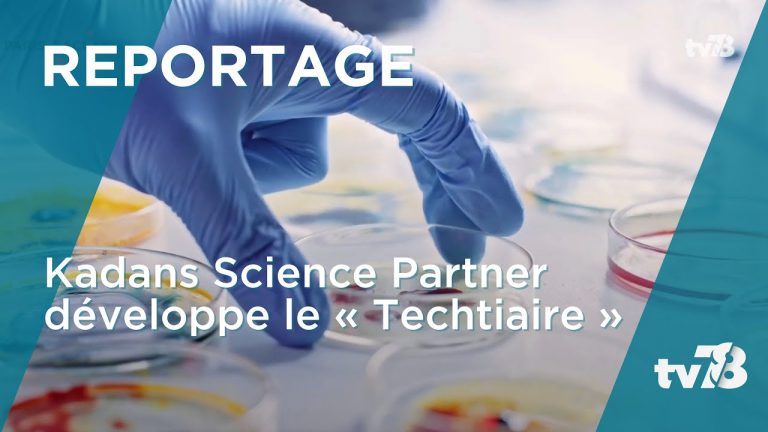
Le projet « techtiaire » de Kadans Science Partner à Paris-Saclay

L’EPA Paris-Saclay a signé avec Kadans Science Partner une promesse de vente d’un terrain situé au sein du Campus urbain, de 14 000m² de surface de plancher, qui comprendra des espaces de travail hybrides, dits « techtiaires ».
Reportage
L’EPA Paris-Saclay a signé avec Kadans Science Partner une promesse de vente d’un terrain situé au sein du Campus urbain, de 14 000m² de surface de plancher, qui comprendra des espaces de travail hybrides, dits « techtiaires ».